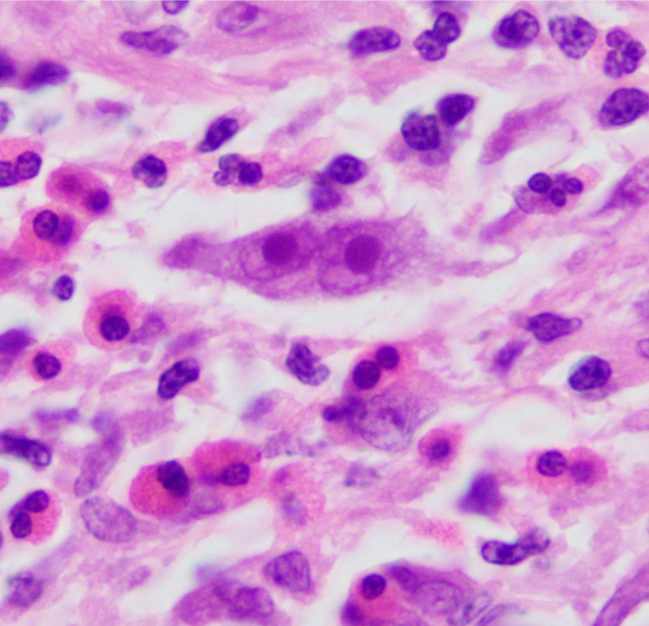
A 28-year-old previously healthy man comes to the office due to episodic fevers, night sweats, and weight loss for several months.  He emigrated from Kenya with his family at age 14.  He does not use tobacco, alcohol, or illicit drugs.  The patient works as a driving instructor and volunteers at a homeless shelter.  His temperature is 37.2 C (99 F) .  Physical examination is normal with the exception of cervical lymphadenopathy.  A lymph node biopsy is performed, and histopathologic findings are shown in the image below.   Which of the following is the most likely diagnosis? A) Burkitt lymphoma B) Follicular lymphoma C) Hodgkin lymphoma D) Large B-cell lymphoma E) Multiple myeloma F) Tuberculosis

A 28-year-old previously healthy man comes to the office due to episodic fevers, night sweats, and weight loss for several months. He emigrated from Kenya with his family at age 14. He does not use tobacco, alcohol, or illicit drugs. The patient works as a driving instructor and volunteers at a homeless shelter. His temperature is 37.2 C (99 F) . Physical examination is normal with the exception of cervical lymphadenopathy. A lymph node biopsy is performed, and histopathologic findings are shown in the image below. Which of the following is the most likely diagnosis?
Which of the following is the most likely diagnosis?
A) Burkitt lymphoma
B) Follicular lymphoma
C) Hodgkin lymphoma
D) Large B-cell lymphoma
E) Multiple myeloma
F) Tuberculosis
Correct Answer:
Verified
Q384: A 7-year-old boy comes to the office
Q385: A 46-year-old smoker presents to your office
Q386: A 3-year-old boy diagnosed with thalassemia major
Q387: A 52-year-old man comes to the office
Q388: A 5-year-old boy is brought to the
Q390: A 35-year-old woman comes to the office
Q391: A 26-year-old woman, gravida 2 para 1,
Q392: A 32-year-old Caucasian woman experiences three episodes
Q393: A 26-year-old Caucasian female is found to
Q394: A 16-year-old previously healthy boy is brought
Unlock this Answer For Free Now!
View this answer and more for free by performing one of the following actions

Scan the QR code to install the App and get 2 free unlocks

Unlock quizzes for free by uploading documents